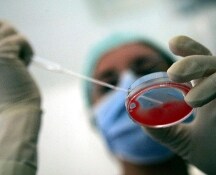

Domenica al voto per il rinnovo del Bundestag

La fine dell'era Merkel e il rebus della nuova maggioranza


Un solo alimentatore per tablet, smartphone, cuffie, console e tutti gli altri dispositivi di qualsiasi marchio. Risparmio per i consumatori stimato in 250 milioni di euro l'anno

La direttiva Avms, approvata nel 2018, prevede un mercato unico per i servizi di radiodiffusione. L'adozione a livello nazionale doveva avvenire entro settembre 2020

Lo zio Danish Hasnain (ritenuto dagli inquirenti l'esecutore materiale dell'omicidio di Saman) fermato ieri in un appartamento di Garges les Gonesse, nella periferia di Parigi dopo mesi di latitanza, al momento non ha rilasciato alcuna dichiarazione

"L'ambizioso piano dell'Unione europea per raggiungere la neutralità climatica rischia di cadere vittima dell'impennata senza precedenti dei prezzi del gas naturale e dell'elettricità", è l'avvertimento dei funzionari di Madrid

A dare la notizia il suo portavoce. Sassoli è vaccinato contro il Covid-19 e nei giorni scorsi era risultato negativo al tampone

"l'Italia- davanti a flussi crescenti via mare legati alle situazioni di grave crisi politica ed economica in cui versano Paesi come la Tunisia e la Libia - attende per i prossimi mesi dai Paesi membri un segnale concreto di solidarietà sul fronte del ricollocamento dei migranti", ha detto il ministro Lamorgese

Andrea Costa, 42 anni, originario di Cuneo, è stato ucciso sabato scorso, dopo una cena con un gruppo di amici. Il suo cadavere è stato scoperto lunedì, ma l'identificazione è arrivata dopo diversi giorni
Vittima una trentenne che abitava a Chivasso

Ospite a Białystok la nipote di Croce, Marta Herling